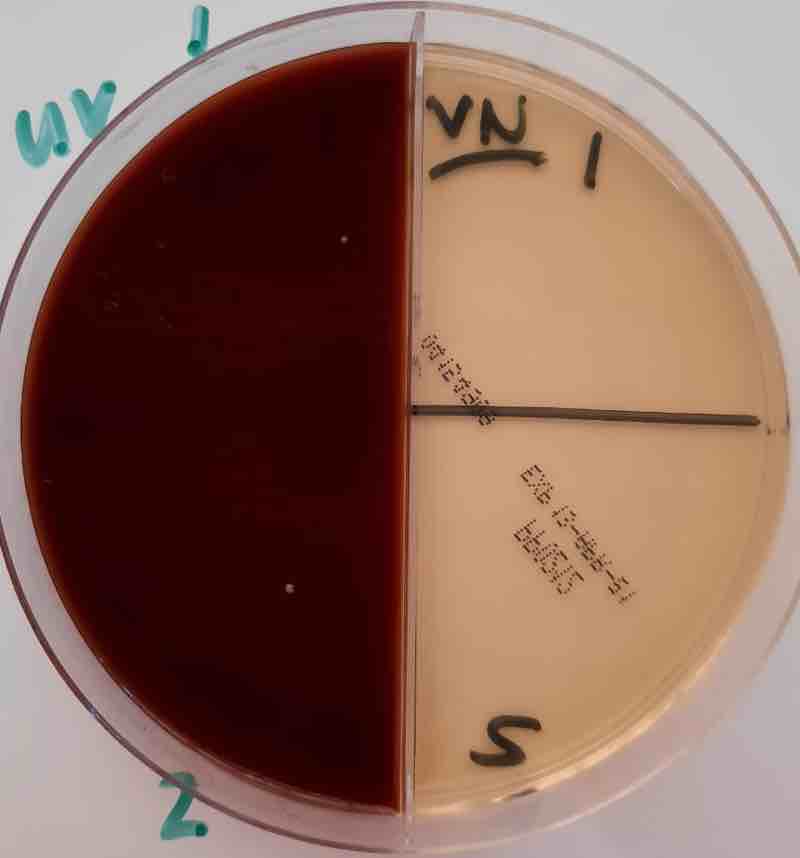
Bacteria in rainwater.

The bacteria in rainwater should be evaluated. Our experience is that stored underground where it is very cold there is little reason to be overly concerned.
But everything is dependent on keeping the gutters relatively free of leaves and debris; that should be done in any case. Cleaning out the pre-reservoir sump regularly is another consideration for those harvesting the rain.
"While the quality of major metropolitan municipalities' drinking water is generally good, about 46% of that in reservoirs in the country is poor or not microbiologically safe to drink."
- 2023 South African Blue Drop report
"The top 2 segments are from the UV-treated water sample; those from the bottom half have not been sterilised. There is one small colony of insignificant growth on the blood agar of each; otherwise no bacteria at all.
Your water sample results above, both straight from the underground reservoir and the UV-treated look good. The two small colonies constitute a very low bacterial load; neither were coloforms which would have shown up as purple."
There is considerable resistance by the general public to building underground reservoirs. Part of this is no doubt based on the cost and the hassle-factor but also the official opinion that rainwater is not potable; in fact potentially dangerous.
There is far greater acceptance of above-ground rainwater tanks, both those of plastic and fibreglass despite the cost and much higher ambient temperature. This is in fact more likely to foster a general risk of bacterial contamination.
"In 81% of cases, water from 140 sewage waste treatment works released into rivers tested in 2023 had not been adequately treated."
- Marais de Vaal, environmentist
After eight years of drinking untreated reservoir rainwater stored underground, with no problems whatsoever we finally succumbed to family pressure and installed filters and a UV-steriliser. It was the right decision seeing that we have the finance to do it.
There is certainly the potential to have bacterial infiltration of rainwater that has been harvested and stored in reservoirs and tanks of any sort.

The fact that it doesn't appear to happen to that stored underground we believe is because of the low temperature; and that any bugs dancing on the hot tin-roof of our home are likely to be killed by the sunshine. Bacteria in rainwater must be considered if it causes diarrhoea; it could happen

The very misleading assumption is that municipal water that has been treated is perfectly safe to drink; nothing could be further from the truth.
Mysteriously globules of liquid-mercury were discharged this week from the taps in Soweto[1]; they were clearly visible but what about all the unseen chemicals and bacteria?
Whilst chlorination was a massive step forwards in preventing serious water-borne diseases, it has created other hazards should there be any organic material in solution. South Africa's inland rivers now are covered with a hyacinth due to untreated sewage that is spewing directly into them; and agricultural runoff of fertiliser and animal waste.
The hyacinth deprives the fish of oxygen; they then die adding to the bacteria in the water.
Chlorination does little to stop contamination in the conduits either; or to remove toxic chemicals, medications and even drugs. Plastic microparticles add to the problem.
"Cape Town residents were issued with a cautionary boil notice because the water-treatment plant was experiencing difficulties due to load shedding."
- Daily Maverick, August, 2022.
In short nothing is perfectly safe; we consider bacteria from rainwater, especially now that we have inserted filters and a UV-lamp far less of a concern as compared to that from the utility. Our local municipality received the lowest Blue Dot score in the country; complete failure[2].
These considerations are weighed in more detail at post-chlorination.
In addition the availability of our water is far more reliable and comes courtesy of the heavens; it's free for those who have taken the trouble to install an underground reservoir.

Our underground rainwater reservoir contains 26,000 litres; about seven-thousand gallons.
If I was to do it again, I would recommend increasing the radius to 2.5 metres; and possibly the depth too, depending on the length of the dry-season. Water solutions need to be constantly rethought and updated.
The mark down on management is due to less than desirable cleaning of the gutters and the sump that traps leaves and debris prior to the rainwater draining into the reservoir. It should be done at least every two months.
The reservoir itself must be completely cleaned at least every second year too.
The bacteria in rainwater are close to zero but what about in tanks and reservoirs?
When browsing use right click and Open Link in New Tab, or you may get a bad gateway signal.
The material expressed on this page is gleaned from the nutritional and environmental literature; it is clearly referenced. A plain distinction is made between the author's opinion and that which is scientifically proven. When in doubt consult your health professional.
To suggest a correction or clarification, write to Dr Bernard Preston here. Contact.
Our newsletter is entitled "create a cyan zone" at your home, preserving both yourself and Mother Earth for future generations; and the family too, of course. We promise not to spam you with daily emails promoting various products. You may get an occasional nudge to buy one of my books.
Here are the back issues.
Did you find this page interesting? How about forwarding it to a friendly book or food junkie? Better still, a social media tick would help.
Address:
56 Groenekloof Rd,
Hilton, KZN
South Africa
Website:
https://www.bernard-preston.com